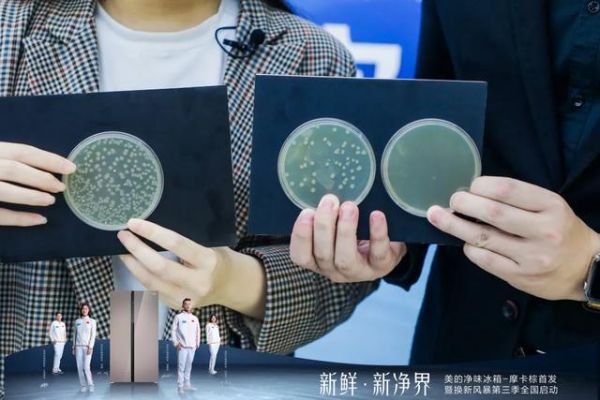

美的净味系列新品发布,打造行业净味标兵
发布时间:2020-06-17 15:52
伴随盛夏到来的,不仅是阳光沙滩
炎炎高温之下,你家的冰箱还好吗
宝宝的果泥,父母的中药
妻子的面膜,丈夫的啤酒
各种“个性”十足的夏日单品
被一股脑塞进了冰箱
味道怎一个“冲”字了得
这个夏天,你需要的是一台
可以19分钟急速净味的美的冰箱
不仅带来清凉,同时畅享清新
6月20日 上午10点,美的直播间
美的净味冰箱·摩卡棕全新发布
为你开启新鲜·新净界

延续第三代PST+超磁电离技术
轻松做到19分钟急速净味
全面、彻底、持久解决异味
搭配全新摩卡棕配色极简面板
长灰拉丝效果,升级金属质感
给你焕然一新的净味体验

直播现场揭晓三大净味场景
共同回顾十吨榴莲净味夺冠赛
19分钟急速净味挑战
现场观察培养皿,进行发霉实验对比
在更健康、更彻底的净味场景中
见证美的不凡品质,打造行业净味标兵
现场更有代言天团重磅揭露
“急速、标兵、冠军”
集美的净味冰箱多重标签于一身
的冠军团队究竟是谁?
新品发布,自然少不了满满福利
“换新风暴”启动仪式现场发布
预售优惠政策,巨献五重好礼
夏季冰箱补贴换新,就在这一趴

活动时间:6月20日 上午 10:00
直播地址:株洲市攸县林森精品综合店交通中路162号
网址:美的净味系列新品发布,打造行业净味标兵 https://c.jiaju82.com/news-view-id-707441.html